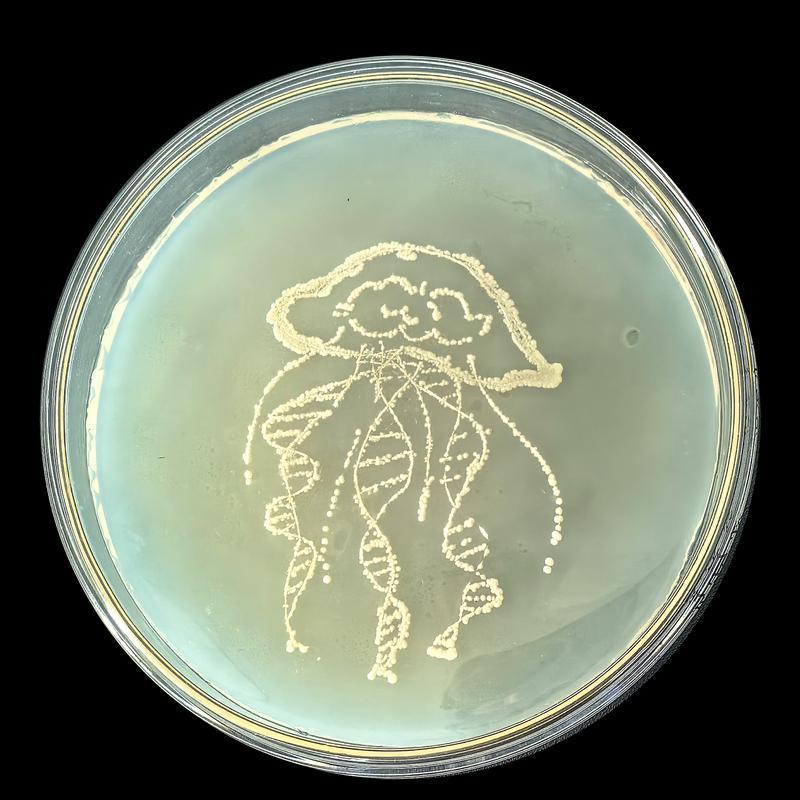

近日,在西安高新第一中学南校区第十三届“华为杯”科技节中,生物学备课组开展的“色彩斑斓”主题系列活动精彩纷呈,其中微生物培养艺术画环节凭借独特的创意形式与科学内涵,成为全场最具惊喜感的亮点。该环节不仅是对学子操作规范与耐心的双重考验,更让高一学子在实践中触摸到生命科学的奇妙魅力。

考虑到高一学子尚未系统学习微生物培养相关知识,为保障活动顺利开展,学校生物备课组提前策划并开展专项培训。培训现场,教师团队将复杂的实验原理转化为通俗讲解,从无菌操作的核心规范、酒精灯的正确使用,到酵母菌接种的精准技巧,逐一拆解每个关键步骤,手把手指导学子掌握实验要领。

培训结束后,各班选派的2名学子化身“微生物画师”,正式投入创作。在无菌操作台的酒精灯火焰旁,他们手持纤细的接种环,蘸取无色透明的酵母菌液,凭借精准手感在培养基上勾勒心中图案。创作过程中,既要时刻规避杂菌污染的风险,还要精准把控接种量以确保后续菌落形态,而所有创作效果当场无法显现,全靠规范操作铺垫期待。

学子们的创意在培养基上肆意流淌:灵动的蝴蝶、飘逸的水母、动漫人物经典造型跃然“纸”上,还有充满活力的火箭、挂满装饰的圣诞树、向阳而生的向日葵,以及鹿等各具特色的形象更是童趣盎然,细细的接种环成为他们手中最特别的“画笔”。

经过数日恒温培养,原本无形的酵母菌在培养基上逐渐繁殖聚集,一幅幅清晰生动的“生物画作”终于揭开面纱。蝴蝶、水母等作品,因菌落分布均匀、线条流畅饱满,充分展现出创作者扎实的操作功底,成功斩获该环节一等奖。

现场展示引得师生们赞叹不已。“用微生物作画,让我们直观感受到了生物学科的独特魅力,更让大家明白,生物学不仅是书本上的原理,更是可触摸、可探索、可创造的鲜活存在。”参与活动的学子纷纷表示。
此次微生物培养艺术画活动,将抽象的生物知识转化为具象的实践体验,既锻炼了学子们的科学素养与动手能力,更点燃了大家对生命科学的探索热情,让生物学知识在心中扎根,让科学探究的习惯伴随成长。
编辑:张芬
相关热词搜索: